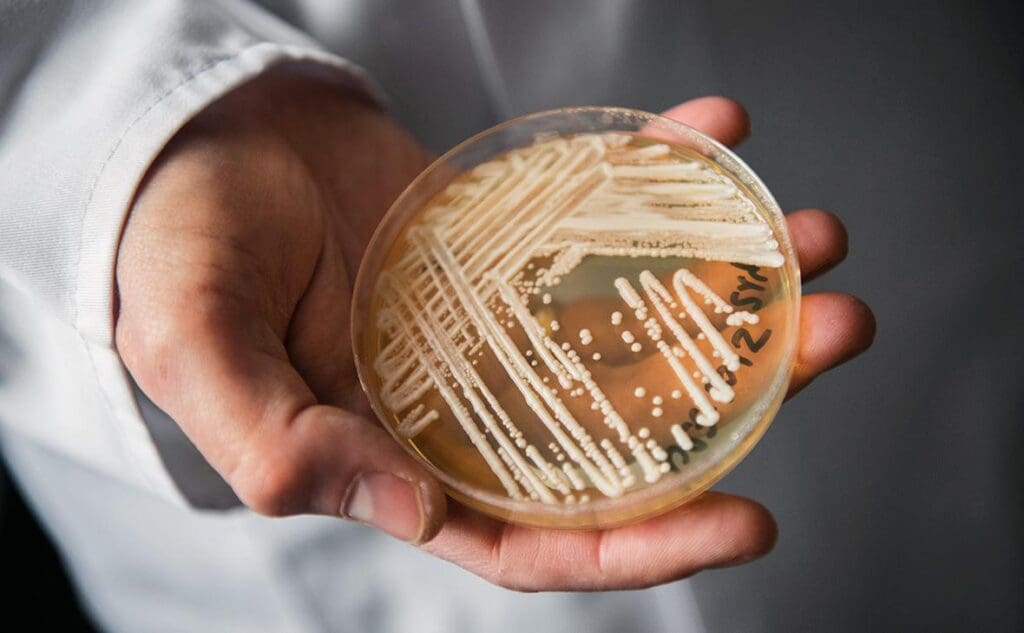

Профиль кандидата: Лига городов и общин (LOC)

Лига городов и общин выдвинула 54 кандидата на парламентские выборы 28 сентября. В списке — несколько мэров и государственных служащих, бывшие члены кабинета министров, врачи, пенсионеры, а также специалисты в различных сферах. Слоган: Лицом к народу Геополитическая ориентация: Европейский союз Первые 10 кандидатов в списке: Александру Бужорян, Константин Кожокарь, Владислав Кочу, Наталия Ремешовски, Григоре Кобзак, Серджиу […]
Как проверить, включены ли вы в список избирателей и где будете голосовать 28 сентября

До парламентских выборов осталось всего девять дней, и граждане Республики Молдова, имеющие право голоса, могут проверить, внесены ли они в списки избирателей, и на какой участок им необходимо явиться для участия в голосовании. Избирательный список — это документ, содержащий всех граждан с правом голоса, которые проживают или имеют временную регистрацию на территории определённого избирательного участка. […]
Promo-Lex: Выявлена сеть фейковых аккаунтов в TikTok, распространяющих ложь перед выборами

Эксперты Promo-Lex, которые наблюдают за избирательной кампанией, обнаружили сеть поддельных аккаунтов в TikTok, распространяющих манипулятивные нарративы накануне выборов. Авторы используют два хэштега — #alegmoldova и #moldova. Всего выявлено 25 основных страниц и около 500 дополнительных, которые за 72 часа собрали примерно 1,3 млн просмотров. Эти аккаунты публиковали одинаковые видео, графические материалы и сообщения, повторяя их […]
16 тысяч евро взятки за «урегулирование» уголовного дела: обыски у пары из столицы

Супружеская пара из столицы подозревается в деле о торговле влиянием. В пятницу, 19 сентября, офицеры Национального центра по борьбе с коррупцией (НЦБК) совместно с прокурорами провели обыски. По данным НЦБК, двое подозреваемых якобы требовали и получили деньги от лиц, фигурирующих в одном уголовном деле, обещая повлиять на государственных служащих для получения благоприятного решения. «Из материалов, […]
Иван Шолтояну: от чемпиона СССР до фигуры криминального мира и политических интриг

Иван Шолтояну, бывший чемпион СССР, обвиняемый в убийстве, по-видимому, сейчас действует лишь в криминальной среде. Согласно источникам и аудиозаписям, поступившим в редакцию stiripesurse.ro, Шолтояну превратился из «простого сельского парня» в теневого переговорщика и посредника в сетях политического влияния, организованных Москвой, пишет онлайн издание. Самый титулованный молдавский спортсмен в боевых единоборствах совершил своё первое убийство в […]
Полярный циклон готовит суровую зиму – прогнозы синоптиков

Над Северным полюсом формируется новый мощный полярный циклон, и синоптики предупреждают, что он может оказать значительное влияние на следующую зиму, в том числе на европейский континент, Канаду и США. Согласно анализу специалистов из Severe Weather, в полярных регионах, в верхней части атмосферы, называемой стратосферой, начинают снижаться давление и температура, что является признаком того, что полярный […]
Этнокультурный фестиваль в Кишинёве: временные ограничения движения в центре города

В связи с проведением Этнокультурного фестиваля движение транспорта будет приостановлено на проспекте Штефан чел Маре, на участке между улицами Митрополит Гавриил Бэнулеску-Бодони и Сфатул Цэрий. Ограничения будут действовать с 08:00 20 сентября до 23:59 21 сентября. Кишинёва власти уточняют, что движение также будет ограничено в периметре Театрального переулка, улиц Триколорулуй и Мария Чеботари. Транспорт, маршрут […]
Румыния ведёт интенсивные переговоры с Европейской комиссией, чтобы не оказаться в энергетическом «блэкауте»

Министр энергетики Румынии Богдан Иван сообщил, что провёл «интенсивные переговоры» в Европейской комиссии, чтобы добиться отсрочки срока, который Румыния обязалась соблюдать относительно закрытия угольных шахт и угольных электростанций к концу этого года, сообщает Agerpres. «Я нахожусь в штаб-квартире Европейской комиссии, где с утра веду интенсивные переговоры вместе с моими коллегами, опираясь на аргументы, которые я […]
Candida Auris стремительно распространяется в больницах Европы
Candida Auris, переименованная в 2023 году в Candidozyma Auris, — лекарственно-устойчивая грибковая инфекция — быстро распространяется в европейских больницах. Центр европейского контроля и профилактики заболеваний (ECDC) призывает к срочным мерам. Инфекция особенно опасна для пациентов в тяжёлом состоянии и тех, кто уже имеет сопутствующие симптомы. Количество случаев растёт, вспышки увеличиваются, и несколько стран сообщают о […]
ЕС ускоряет отказ от российского СПГ по просьбе Трампа

Европейский Союз намерен ускорить отказ от сжиженного природного газа (СПГ) из России в ответ на просьбу президента США Дональда Трампа, который призвал блок активизировать усилия по снижению энергетической зависимости от Москвы. Европейская комиссия рассматривает возможность включения положения в новый пакет санкций, которое позволит постепенно сократить импорт российского СПГ до конца 2027 года, сообщили источники, знакомые […]